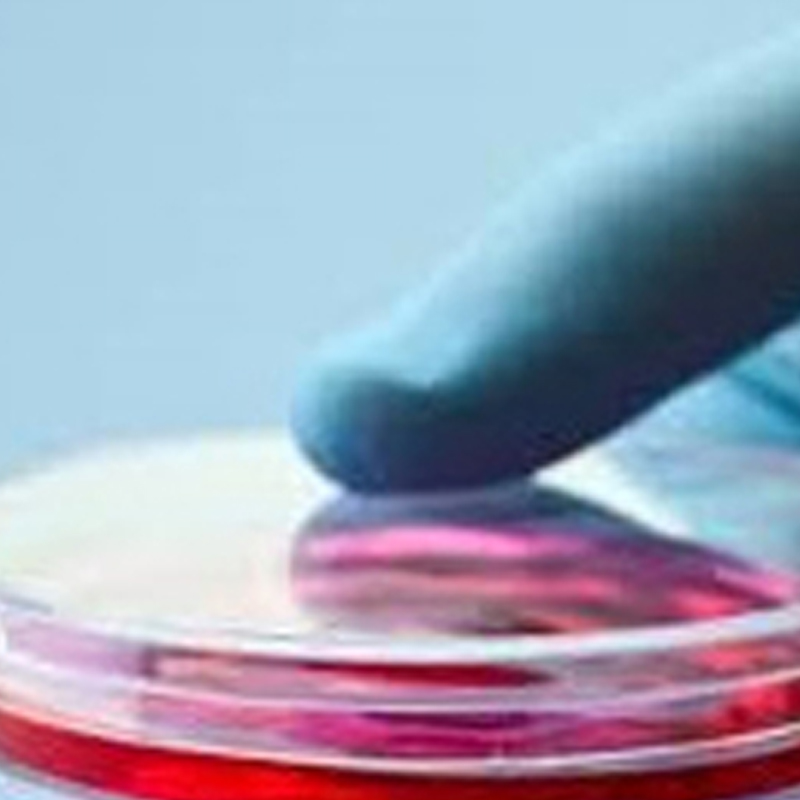

LCI產(chǎn)制滿足各種應(yīng)用培養(yǎng)系統(tǒng)






Multistep paradigm for leukocyte recruitment
(a)Model of a post-capillary venule illustrating the four steps of leukocyte recruitment.These are(1)initial attachment(2)low-velocity rolling(3)arrest and activation of leukocyte integrin via locally expressed chemokines and(4)transmigration.(b)Fluid shear stress.In small venules,flow has been calculated as laminar shear stress with a parabolic velocity profile(minimum velocity at the vessel wall,maximum at the center line of the vessel).Fluid shear stress also can act directly on endothelial cells and T cells.(EC,endothelial cell;BM,basement membrane.)(Reprinted with permission from Alper,J.Searching for medicine's sweet spot.Science 291,2338?2243(2001).).Copyright American Association for the Advancement of Science.Original illustration by C.Cain,redrawn by B.Crimi.)











-

生物指示劑培養(yǎng)器
-

生物指示劑培養(yǎng)器
-

活細胞培養(yǎng)系統(tǒng)
-

磁石培養(yǎng)皿
-

μ-Slide I 單通道玻璃底培養(yǎng)載玻片
-

常規(guī)培養(yǎng)基
-

μ-Slide 18孔培養(yǎng)載玻片-81821 81822 81823 81824 81825 81826 81831
-

無血清培養(yǎng)基
-

細胞培養(yǎng)試劑
-

原代細胞及推薦培養(yǎng)基
-

DIC培養(yǎng)皿蓋/載玻片蓋
-

μ-Slide 單通道3D培養(yǎng)載玻片
-

磁座組合式活細胞培養(yǎng)槽
-

玻璃底培養(yǎng)皿
-

μ-Slide球體灌注通道培養(yǎng)載玻片80356 80350 80351
-

彈性底部培養(yǎng)皿
-

細胞定位格子培養(yǎng)皿
-

細胞培養(yǎng)皿
-

細胞定位格子培養(yǎng)皿
-

細胞定位格子培養(yǎng)皿
-

共培養(yǎng)載玻片
-

培養(yǎng)皿顯微鏡架
-

35毫米低壁培養(yǎng)皿
-

50毫米低壁培養(yǎng)皿
-

培養(yǎng)皿載玻片保濕盒